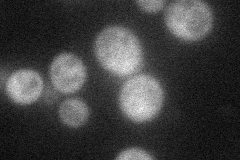
YPR042C
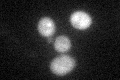
YPR042C

View description
Member of the PUF protein family, which is defined by the presence of Pumilio homology domains that confer RNA binding activity; preferentially binds mRNAs encoding membrane-associated proteins
Localization:
Intensity:
Fold change:
Significance:
-
C’ GFP library in SD

cytosol33.11 -
N' NOP1pr-GFP in SD
cytosol35.4284 -
N' TEF2pr-mCherry in SD

cytosol23.0951 -
N' NATIVEpr-GFP in SD

punctate24.9569 -
N' TEF2pr-VC and Cyto-VN in SD

#N/A0 -
C’ GFP library in SD+DTT
cytosol29.750.89No -
C’ GFP library in SD+H2O2

cytosol41.411.25No -
C’ GFP library in Starvation Media

cytosol34.931.05No -
C’ GFP library on the background of Pup2-DaMP

cytosol -
C’ GFP library on the background of CCT mutant

cytosol29.55780.892484No
